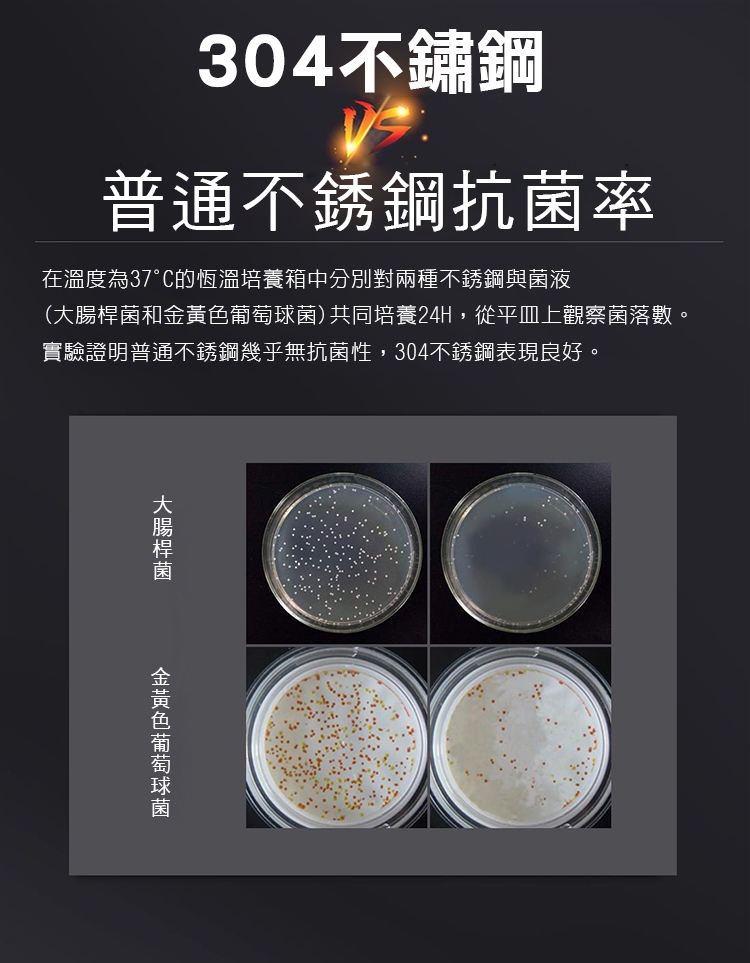

商品詳細介紹

體驗說明
不可體驗
使用方法說明
產品特點:環保衛生,耐磨損,熱膨脹性能和保溫性能高
注意事項
■收到商品後,請先檢查是否有瑕疵或是寄錯,如超出期限才發現有問題,恕無法受理逾期的商品。
■線頭、輕微脫線、極小的汙點、尺寸2~3cm的誤差、螢幕色差、扣眼未開等...在國際驗貨標準都是屬於可接受的範圍,並不屬於瑕疵。
■退回商品需包裝完好無損和附件齊全,不影響二次銷售之全新商品;若商品有附夾鏈袋、紙盒等特殊包裝也需保持完整無任何毀損並一同退回,如有毀損恕無法接受退貨;盒類商品〈如鞋靴類/帽類〉請使用無油墨之包裝紙/紙袋/紙箱包裝〈請勿直接於商品配件上黏貼退貨單〉,以及退貨之商品需尚未下水且吊牌完整(吊牌未拆剪),若有使用過及特殊異味「如香水、菸味、衣櫃芳香劑、及其它不明異味」之情形,將導致商品無法正常辦理退換貨!
■七天鑑賞期根據消費者保護法之規定,賣場將提供您享有商品到貨七天猶豫期隨時解約退貨之權益,退貨時必須為全新狀態及完整包裝(包含:內外包裝、贈品等)。如吊牌拆除或遺失、已使用、洗滌過的商品,恕無法接受退換。
■貼身內著類衣物為確保衛生原則,恕無提供退貨服務。
■為了避免因商品尺寸不合,減少您對商品退貨及退款需等待更長時間所產生的困擾,建議買家們在訂購前可先參考各款尺寸表及試穿報告。
■線頭、輕微脫線、極小的汙點、尺寸2~3cm的誤差、螢幕色差、扣眼未開等...在國際驗貨標準都是屬於可接受的範圍,並不屬於瑕疵。
■退回商品需包裝完好無損和附件齊全,不影響二次銷售之全新商品;若商品有附夾鏈袋、紙盒等特殊包裝也需保持完整無任何毀損並一同退回,如有毀損恕無法接受退貨;盒類商品〈如鞋靴類/帽類〉請使用無油墨之包裝紙/紙袋/紙箱包裝〈請勿直接於商品配件上黏貼退貨單〉,以及退貨之商品需尚未下水且吊牌完整(吊牌未拆剪),若有使用過及特殊異味「如香水、菸味、衣櫃芳香劑、及其它不明異味」之情形,將導致商品無法正常辦理退換貨!
■七天鑑賞期根據消費者保護法之規定,賣場將提供您享有商品到貨七天猶豫期隨時解約退貨之權益,退貨時必須為全新狀態及完整包裝(包含:內外包裝、贈品等)。如吊牌拆除或遺失、已使用、洗滌過的商品,恕無法接受退換。
■貼身內著類衣物為確保衛生原則,恕無提供退貨服務。
■為了避免因商品尺寸不合,減少您對商品退貨及退款需等待更長時間所產生的困擾,建議買家們在訂購前可先參考各款尺寸表及試穿報告。